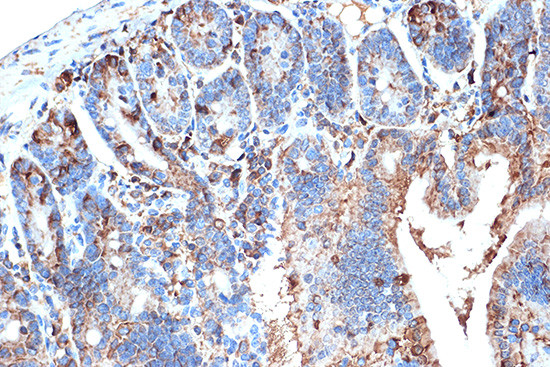
FABP2 Antibody in Immunohistochemistry (Paraffin) (IHC (P))

Search
Invitrogen
FABP2 Recombinant Rabbit Monoclonal Antibody (5W9L6)
{{$productOrderCtrl.translations['antibody.pdp.commerceCard.promotion.promotions']}}
{{$productOrderCtrl.translations['antibody.pdp.commerceCard.promotion.viewpromo']}}
{{$productOrderCtrl.translations['antibody.pdp.commerceCard.promotion.promocode']}}: {{promo.promoCode}} {{promo.promoTitle}} {{promo.promoDescription}}. {{$productOrderCtrl.translations['antibody.pdp.commerceCard.promotion.learnmore']}}
图: 1 / 4
FABP2 Antibody (MA5-35731) in IHC (P)




Please note: We are reviewing Western blot images included in the antibody testing data in our catalog, including those provided by third parties. Unless expressly labeled or annotated as “raw-unedited”, Western blot images included in the antibody testing data in our catalog may have been edited, optimized or otherwise adjusted for presentation.
产品信息
MA5-35731
种属反应
宿主/亚型
Expression System
分类
类型
克隆号
抗原
偶联物
形式
浓度
规格
纯化类型
保存液
内含物
保存条件
运输条件
RRID
产品详细信息
Immunogen sequence: MAFDSTWKVD RSENYDKFME KMGVNIVKRK LAAHDNLKLT ITQEGNKFTV KESSAFRNIE VVFELGVTFN YNLADGTELR GTWSLEGNKL IGKFKRTDNG
靶标信息
The FABP2 gene encodes the intestinal fatty acid-binding protein 2 (I-FABP), which plays a significant role in lipid metabolism by facilitating the transport and intracellular trafficking of long-chain fatty acids in enterocytes, the absorptive cells in the intestine. FABP2 is involved in the uptake, metabolism, and transfer of fatty acids across cellular membranes, contributing to digestion and absorption processes in the intestine. This protein is crucial for efficient lipid metabolism, influencing fatty acid oxidation, and energy balance. Variations in the FABP2 gene have been associated with metabolic traits, such as insulin sensitivity, lipid profiles, and obesity, suggesting its impact on metabolic health. FABP2's function in intestinal lipid absorption and metabolism makes it a subject of interest in studies related to dietary effects on health and the development of metabolic disorders. Understanding FABP2's role is essential for insights into nutritional influences on health and possible therapeutic targets for metabolic diseases.
仅用于科研。不用于诊断过程。未经明确授权不得转售。
篇参考文献 (0)
生物信息学
蛋白别名: FABPI; fatty acid binding protein 1; Fatty acid-binding protein 2; Fatty acid-binding protein, intestinal; I-FABP; intestinal fatty acid binding protein; intestinal fatty acid binding protein 2; Intestinal-type fatty acid-binding protein; MGC133132
基因别名: FABP; Fabp2; Fabpi; I-FABP
UniProt ID: (Mouse) P55050, (Rat) P02693
Entrez Gene ID: (Mouse) 14079, (Rat) 25598